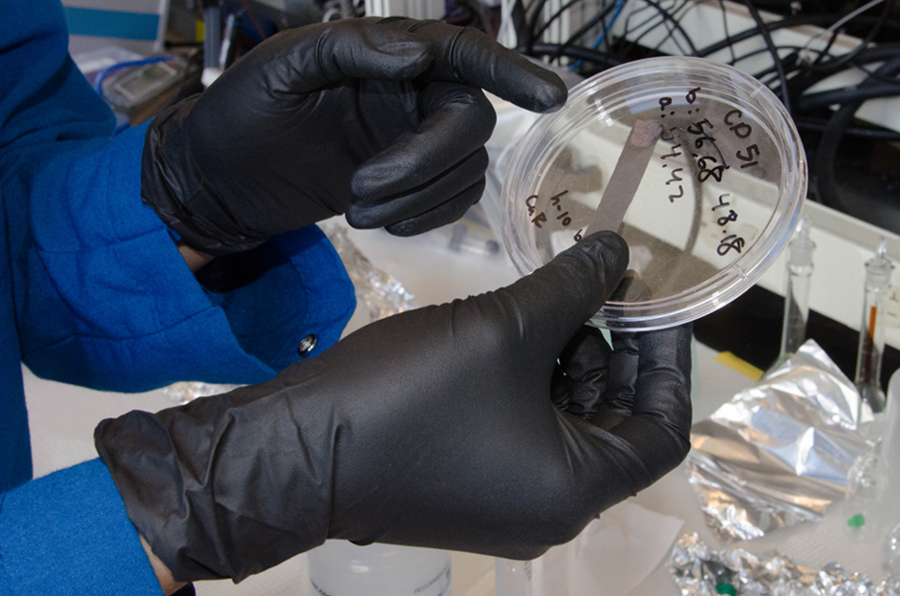

A convection oven cooks more uniformly because a fan creates a steady flow of hot air around the food being cooked. The research group of Fikile R. Brushett, the Raymond A. (1921) and Helen E. St. Laurent Career Development Professor of Chemical Engineering, is applying that principle to a new water-based battery design that pumps a steady flow of charge-carrying ions through a battery to create a more uniform distribution of ions in the cell.
“We’re fabricating an aqueous [water-based] battery which is safe, cheap, and scalable,” says Victoria Yao, a Materials Processing Center (MPC)-Center for Materials Science and Engineering (CMSE) Summer Scholar in the Brushett Research Group. A rising junior at Vanderbilt University, Yao is majoring in chemical engineering. This summer, she worked with graduate student Thomas J. Carney to develop a convection cell battery, in which electrolyte would flow through the electrode material, rather than remain static as in a conventional battery.
Prussian blue materials
During her summer internship in the Brushett group, Yao synthesized electrode materials in the same chemical family as Prussian blue, which is commonly used to dye fabric and to color makeup such as eye shadow. Prussian blue is the common name for ferric ferrocyanide, but unlike some highly poisonous cyanide compounds, Prussian blue is considered non-toxic and is even ingested to treat radiation poisoning.
Yao created the Prussian blue-like materials in a liquid solution of metal nitrates, adding the chemical compound potassium hexacyanoferrate to precipitate the desired compounds, such as copper hexacyanoferrate. An inorganic compound, sodium thiosulfate, is added to make the particles bigger and change the amount of energy stored in the material. She then separated out the particles with a filter or centrifuge. Once dried, the colorful particles were mixed with additives to make “inks” that can be precisely dripped on carbon paper to form thin electrodes for battery testing. “Immediately after you make the ink, you need to pipette it onto carbon paper, let it dry, and then remove any contaminants under vacuum,” Yao says.
These thin electrode cells were tested in a flow-through reactor — an arrangement of glass components in an “H” configuration — that runs for hours at a time, sometimes overnight, to gather sufficient data to measure their capacity and efficiency. In the reactor, the carbon-paper electrodes are placed in the upright glass tubes with a sodium chloride (table salt) solution connecting the two through the middle. After adding a reference electrode, Yao bubbled argon gas through the experimental setup.
“I’ve made eight different powders, and tested their energy storage properties with thin electrodes,” she says.
After making and testing thin electrodes, Yao planned to move to producing thick porous electrodes, which could yield higher energy density. These thick electrodes require more raw material, which is compressed into pellets.
In presenting this project, called Convection Enhanced Electrochemical Energy Storage, to Summer Scholars in June, Brushett said, “We’ve got a proof of concept, and we’re really excited. ... Ideally we’d like to translate this proof-of-concept device into a little canister-like flow cell with thick porous electrodes and pump electrolyte through the reactor ... and there we should have our convection battery.”
Open framework for ions
"Prussian blue-related chemical compounds have an open framework that allows ions to move in and out of the two battery electrodes while remaining solvated (bound to water molecules) by the electrolyte solution which, in turn, enables fast reactions," Brushett says. "When coupled with a flowing electrolyte we may be able to develop energy dense batteries with thick electrodes and tunable power output." The project fits into the Brushett group’s larger goal of helping to build a sustainable energy economy through innovative, new energy storage technologies.
"Victoria has been instrumental in synthesizing and characterizing Prussian blue analogue materials for use in convection-based energy storage devices this summer. The MPC-CMSE Summer Scholar’s program provides opportunities for talented undergraduates from across the country to work on cutting-edge research projects here at MIT," Brushett says. "Not only do these students learn of the discipline, tenacity, and creativity required to perform fundamental research but our graduate students learn how to mentor enthusiastic but less experienced lab workers. Her dedication and aptitude have directly accelerated our research! We are very happy to have hosted her this summer."
The MPC and CMSE sponsor the nine-week National Science Foundation (NSF) Research Experience for Undergraduates (NSF REU) internships, with support from NSF’s Materials Research Science and Engineering Centers program. The Summer Scholars program ran from June 7 through Aug. 6.